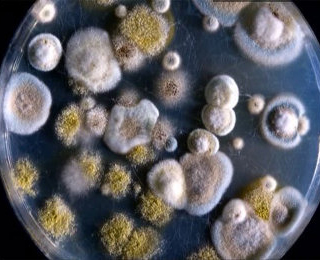
Плесень как причина развития заболевания Плесень

Один из самых распространенных видов аллергии – аллергия на грибок и плесень (грибковая аллергия). Споры грибов распространены в воздухе практически повсеместно – порой их количество превышает количество пыльцы, что приводит к высокому риску возникновения ответной реакции.
Грибковая аллергия и ее причины
Такая аллергия может возникнуть как у ребенка, так и у взрослого человека.
В зависимости от сезона возрастает риск развития заболевания. Если летом и осенью наибольший риск контакта с аллергеном возникает на улице, то в зимний период – дома.
Пик угрозы развития перекрестной аллергии на грибок и плесень приходится на осень, поэтому ее называют “осенней аллергией”.
Причиной развития заболевания могут быть:
- плесень;
- грибные поражения древесины (синева, гниль);
- актиномицеты.
Плохо вентилируемые, отсыревшие помещения являются распространенным источником плесени, выглядящей как пятна или разноцветные точки.
Оптимальными условиями развития грибка обладают подвальные помещения, комнаты с повышенной влажностью, вентиляционные системы.
В квартире аллерген может появиться в цветочном горшке, кондиционере. Такие промышленные предприятия, как молокозаводы, пивоварни, использующие продукты брожения, находятся в группе риска.
Другой вид аллергена – грибки синевы (синь древесины). Они выглядят как сине-серые пятна на деревянной поверхности. Древесная гниль также вызывает изменение цвета, при этом меняется структура дерева (понижается твердость и прочность). Дома из дерева, деревянные полы и стены могут быть подвержены этим грибкам.
Актиномицеты – это микроскопические организмы, занимающие промежуточное место между грибами и водорослями. Благоприятной средой обитания для них является почва. Актиномицеты – источники такого хронического заболевания как актиномикоз.
Актиномикоз может передаваться как животному, так и человеку. Появлению различных микозов способствуют длительное употребление антибиотиков, снижение иммунитета.
Провоцируют появление грибковой аллергии такие факторы:
- наследственность или врожденная предрасположенность;
- нахождение в помещениях, являющихся источником плесени;
- инфицированный грунт для комнатных растений;
- постоянно работающий кондиционер в помещении;
- сезонные работы;
- уборка прелых листьев;
- некоторые виды профессиональной деятельности под землей (в шахте, метро);
- продукты, содержащие плесень.
Аллерген попадает в организм человека двумя способами:
- вместе с пищей;
- респираторным путем (через воздух).
Мнение врачей:
Грибковая аллергия проявляется различными симптомами, такими как зуд, покраснение кожи, отеки и высыпания. Важно обратиться к врачу при первых признаках, чтобы получить правильное лечение. Врачи рекомендуют применять антигрибковые мази и кремы для лечения пораженных участков кожи. Также в некоторых случаях могут назначаться противогрибковые препараты для внутреннего приема. Важно помнить, что самолечение может усугубить состояние, поэтому следует следовать рекомендациям специалиста и не откладывать поход к врачу.

Симптомы грибковой аллергии
Выявить грибковую аллергию можно путем аллергических проб на коже или по наличию специфического антигена в крови. Характерный ряд симптомов также помогает выявить ответную иммунную реакцию на грибы и плесень:
- заложенность носа;
- повышенное слезотечение;
- зуд и жжение в глазах;
- чихание;
- кашель;
- прослушиваемые в легких хрипы;
- одышка;
- поверхностные микозы (лишаи);
- появление бронхиальной астмы;
- появление аллергического ринита.
Кожная аллергическая реакция
Аллергия на коже может возникнуть вследствие неправильного питания (употребления в пищу теста, пива, просроченных продуктов).
Под кожными аллергическими заболеваниями, спровоцированными грибком, подразумеваются различные дерматозы и микозы со следующими симптомами:
- покраснение кожи;
- зуд;
- отечность.

Опыт других людей
Грибковая аллергия – это состояние, при котором организм реагирует на грибковые споры, вызывая различные симптомы. Люди, столкнувшиеся с этой аллергией, часто отмечают зуд, красные пятна на коже, насморк, чихание и затрудненное дыхание. Для диагностики и лечения грибковой аллергии необходимо обратиться к аллергологу. Часто назначаются антигистаминные препараты, кремы от зуда и специальные препараты для уменьшения реакции организма. Важно избегать контакта с грибками и соблюдать рекомендации врача для предотвращения обострений аллергии.
Грибковый аллергический ринит
Хронический аллергический ринит, вызванный грибком, обостряется в весенне-летний период. Зачастую у больных отмечается наличие сопутствующих иммунных реакций (таких как пищевая аллергия).
Провоцируют болезнь сырость помещений, плесень.
Симптомы грибкового аллергического ринита следующие:
- насморк;
- чихание;
- зуд в носу;
- отечность слизистой оболочки носа.
Грибковая бронхиальная астма
Плесневые грибы увеличивают риск появления бронхиальной астмы. Наибольшее количество спор в воздухе отмечено в осенне-зимний период.
Заболевание может возникнуть вследствие длительного пребывания в сыром помещении, после употребления в пищу некоторых продуктов (кисломолочные продукты, грибы; возможна даже аллергия на пиво).
У больных наблюдаются следующие симптомы:
- хрипы в легких;
- кашель;
- мокрота;
- отечность слизистой оболочки гортани;
- затрудненное дыхание;
- состояние анафилактического шока.
Профилактика и лечение грибковой аллергии
При первых признаках симптомов грибковой аллергии следует обратиться к специалисту. Необходимо пройти осмотр у таких врачей, как аллерголог и миколог.
Устранение симптомов проводится такими же способами, что и при обычной аллергии. При лечении грибковой аллергии используются следующие методы:
- при насморке рекомендуется промывать нос щелочным раствором (с использованием морской соли);
- назначаются антигистаминные и гормональные таблетки;
- используются гормональные, негормональные мази;
- симптомы купируются различными спреями, каплями и ингаляторами;
- проводится вакцинация для выработки иммунитета;
- применяется аутолимфоцитотерапия (метод использования собственных лимфоцитов больного);
- используются средства народной медицины, такие как отвары трав, настойки.
Во избежание болезни следует избавиться от всех возможных источников аллергена:
- регулярно проводить влажную уборку;
- пылесосить;
- хорошо проветривать помещения;
- не допускать возникновения сырости в помещении;
- убрать из дома все вещи, содержащие грибок или плесень;
- следить за состоянием комнатных растений;
- не допускать проникновение влаги в стены помещения; sexpromo
- применять антисептики (противогрибковые препараты) во время уборки.
Для профилактики заболевания рекомендуется исключить из рациона ряд продуктов, содержащих плесень либо продукты брожения:
- сыры (особенно распространена аллергия на сыр с плесенью);
- творог;
- кефир;
- йогурт;
- некоторые алкогольные напитки (квас, пиво, вино, шампанское);
- дрожжевую выпечку;
- соленья и квашения;
- может быть аллергия на сахар;
- фруктозу и т.д.
Грибковая аллергия считается одним из самых распространенных заболеваний.
Она характеризуется смешанными иммунными реакциями и разнообразием клинических форм – от кожных до респираторных болезней.
Вовремя не проведенное лечение может стать причиной развития таких серьезных осложнений, как хроническая астма.
Источники: medscape.com, mdlinx.com,
health.harvard.edu.
Частые вопросы
Как проявляется грибковая аллергия?
Как проявляется грибковая аллергия? Основными симптомами грибковой аллергии являются заложенность носа и слезотечение, резь в глазах и зуд, приступы кашля, хрипы в груди и чихание. Нередко при такой аллергии у пациента наблюдаются высыпания на коже.
Что нельзя при грибковой аллергии?
Исключите или ограничьте употребление в пищу продуктов, содержащих аллергены грибов: грибы, острые сыры («Рокфор», «Чеддер», «Дорблю»), квас, пиво, вино, шампанское, виноград и сухофрукты, некоторые кисломолочные продукты, дрожжевое тесто.
Как избавиться от аллергии на грибы?
Аллергия на грибы и плесень встречается у взрослых и детей. Рекомендуемые методы лечения – это устранение контакта с аллергеном и прием антигистаминных препаратов (различные таблетки и дорогие лекарства). Они эффективны только в отношении симптомов и оказывают лишь временный эффект.
Что такое грибковые аллергены?
Грибковые аллергены – это аллергены спор грибов, живущие в окружающей среде. Они бывают двух видов: дрожжевые, плесневые.
Полезные советы
СОВЕТ №1
При первых признаках грибковой аллергии обратитесь к врачу для точного диагноза и назначения правильного лечения.
СОВЕТ №2
Избегайте контакта с возможными источниками грибковой аллергии, такими как плесень, грибки на почве или растениях.
СОВЕТ №3
Следите за состоянием своей кожи и слизистых оболочек, так как грибковая аллергия часто проявляется сыпью, зудом, отеками или нарушениями дыхания.